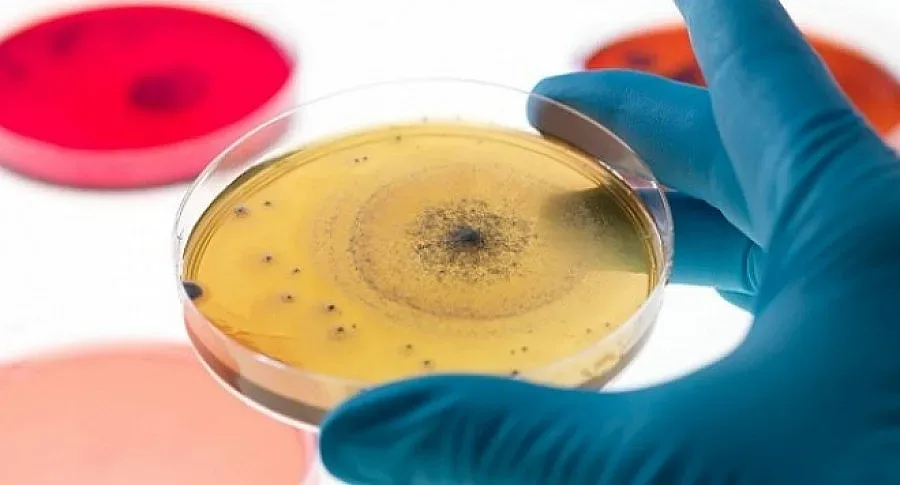

За десетилетие новата терапия би спестила 1 млрд. лв., изчислява проф. Искрен Коцев
Около 150 болни от цялата страна чакат нов живот с новата революционна терапия срещу хепатит С. Списъкът с имената им е представен в здравното министерство и НЗОК с молба да бъдат покрити разходите им по спешното лечение, което засега е много скъпо, каза проф. д-р Искрен Коцев, ръководител на клиниката по хепатогастроентерология в УМБАЛ "Св. Марина", който наскоро се завърна от годишната среща на Европейската асоциация за изучаване на черен дроб във Виена. Форумът е дал пълна подкрепа на съвременното перорално лечение на хепатит С.
Новата терапия с комбинация от хапчета дава надежди за тотално изкореняване на коварната зараза в близко бъдеще. Революционното лечение помага дори на хора с тежки усложнения като фиброза и цироза, на които досегашните инжекции и таблетки против хепатит С не помагаха, а и даваха много странични ефекти. Новите хапове вече са признати от агенциите по лекарствата в САЩ, ЕС и у нас. За да влязат в употреба, трябва да бъдат включени в Позитивния списък на здравната каса. Причината е, че малко хора могат да си позволят
да платят 80-120 000 лв. за един курс
от 3-месечно лечение. Производителите дават вече до 30 на сто отстъпка, но и с нея цената е непосилна за повечето болни, коментира проф. Коцев.
8 пациенти на клиниката във варненската болница вече са лекувани с хаповете благодарение на дарение от фирмата производител. Болните са страдали от чернодробна цироза след заразяване с хепатит С. Само за 3 месеца е ликвидиран опасният вирус, според резултатите от първите тестове, които трябва да се потвърдят след повторни изследвания след 3 месеца, обясни професорът. Според него срокът за един лечебен курс се съкращава с новата терапия двойно, а ефектът се повишава от 60-65% на 90-95%. Той е убеден, че тя ще бъде приета от здравното министерство и НЗОК, защото за 10 г. би спестила близо 1 млрд. лева за лечение на чернодробни усложнения. Но за това е необходимо да се разшири и скринингът, тъй като болестта протича без симптоми, заразените не разбират, че са болни, докато не станат хроници и не ги застигнат тежките усложнения - цироза и чернодробен карцином. При трезвениците това се случва за период от 20-40 г., а
при пиещите алкохол - след 10-12 г.
Само в УМБАЛ "Св. Марина" за последните 5 г. броят на болните от хепатит С се е увеличил двойно и сега годишно се лекуват по 300 души, колкото и от хепатит В. Почти 1/4 от пациентите са с цироза.
Всеки българин веднъж годишно трябва да си прави пълния панел изследвания за хепатит В и С, препоръчват специалистите. Кръвните тестове са особено наложителни за феновете на татуировките и пиърсинга, за интравенозните наркомани или на хората, на които им е преливана кръв преди 1992 г., когато вирусът на хепатит С е все още не дотам познат. Заразата може да се прихване при хирургическа намеса, в зъболекарския кабинет, но досега такива случаи във Варна няма. Изследването за хепатит В и С може да се направи с направление от джипито.
Последвайте ни в Google News Showcase за важните новини
Вижте всички актуални новини от Standartnews.com